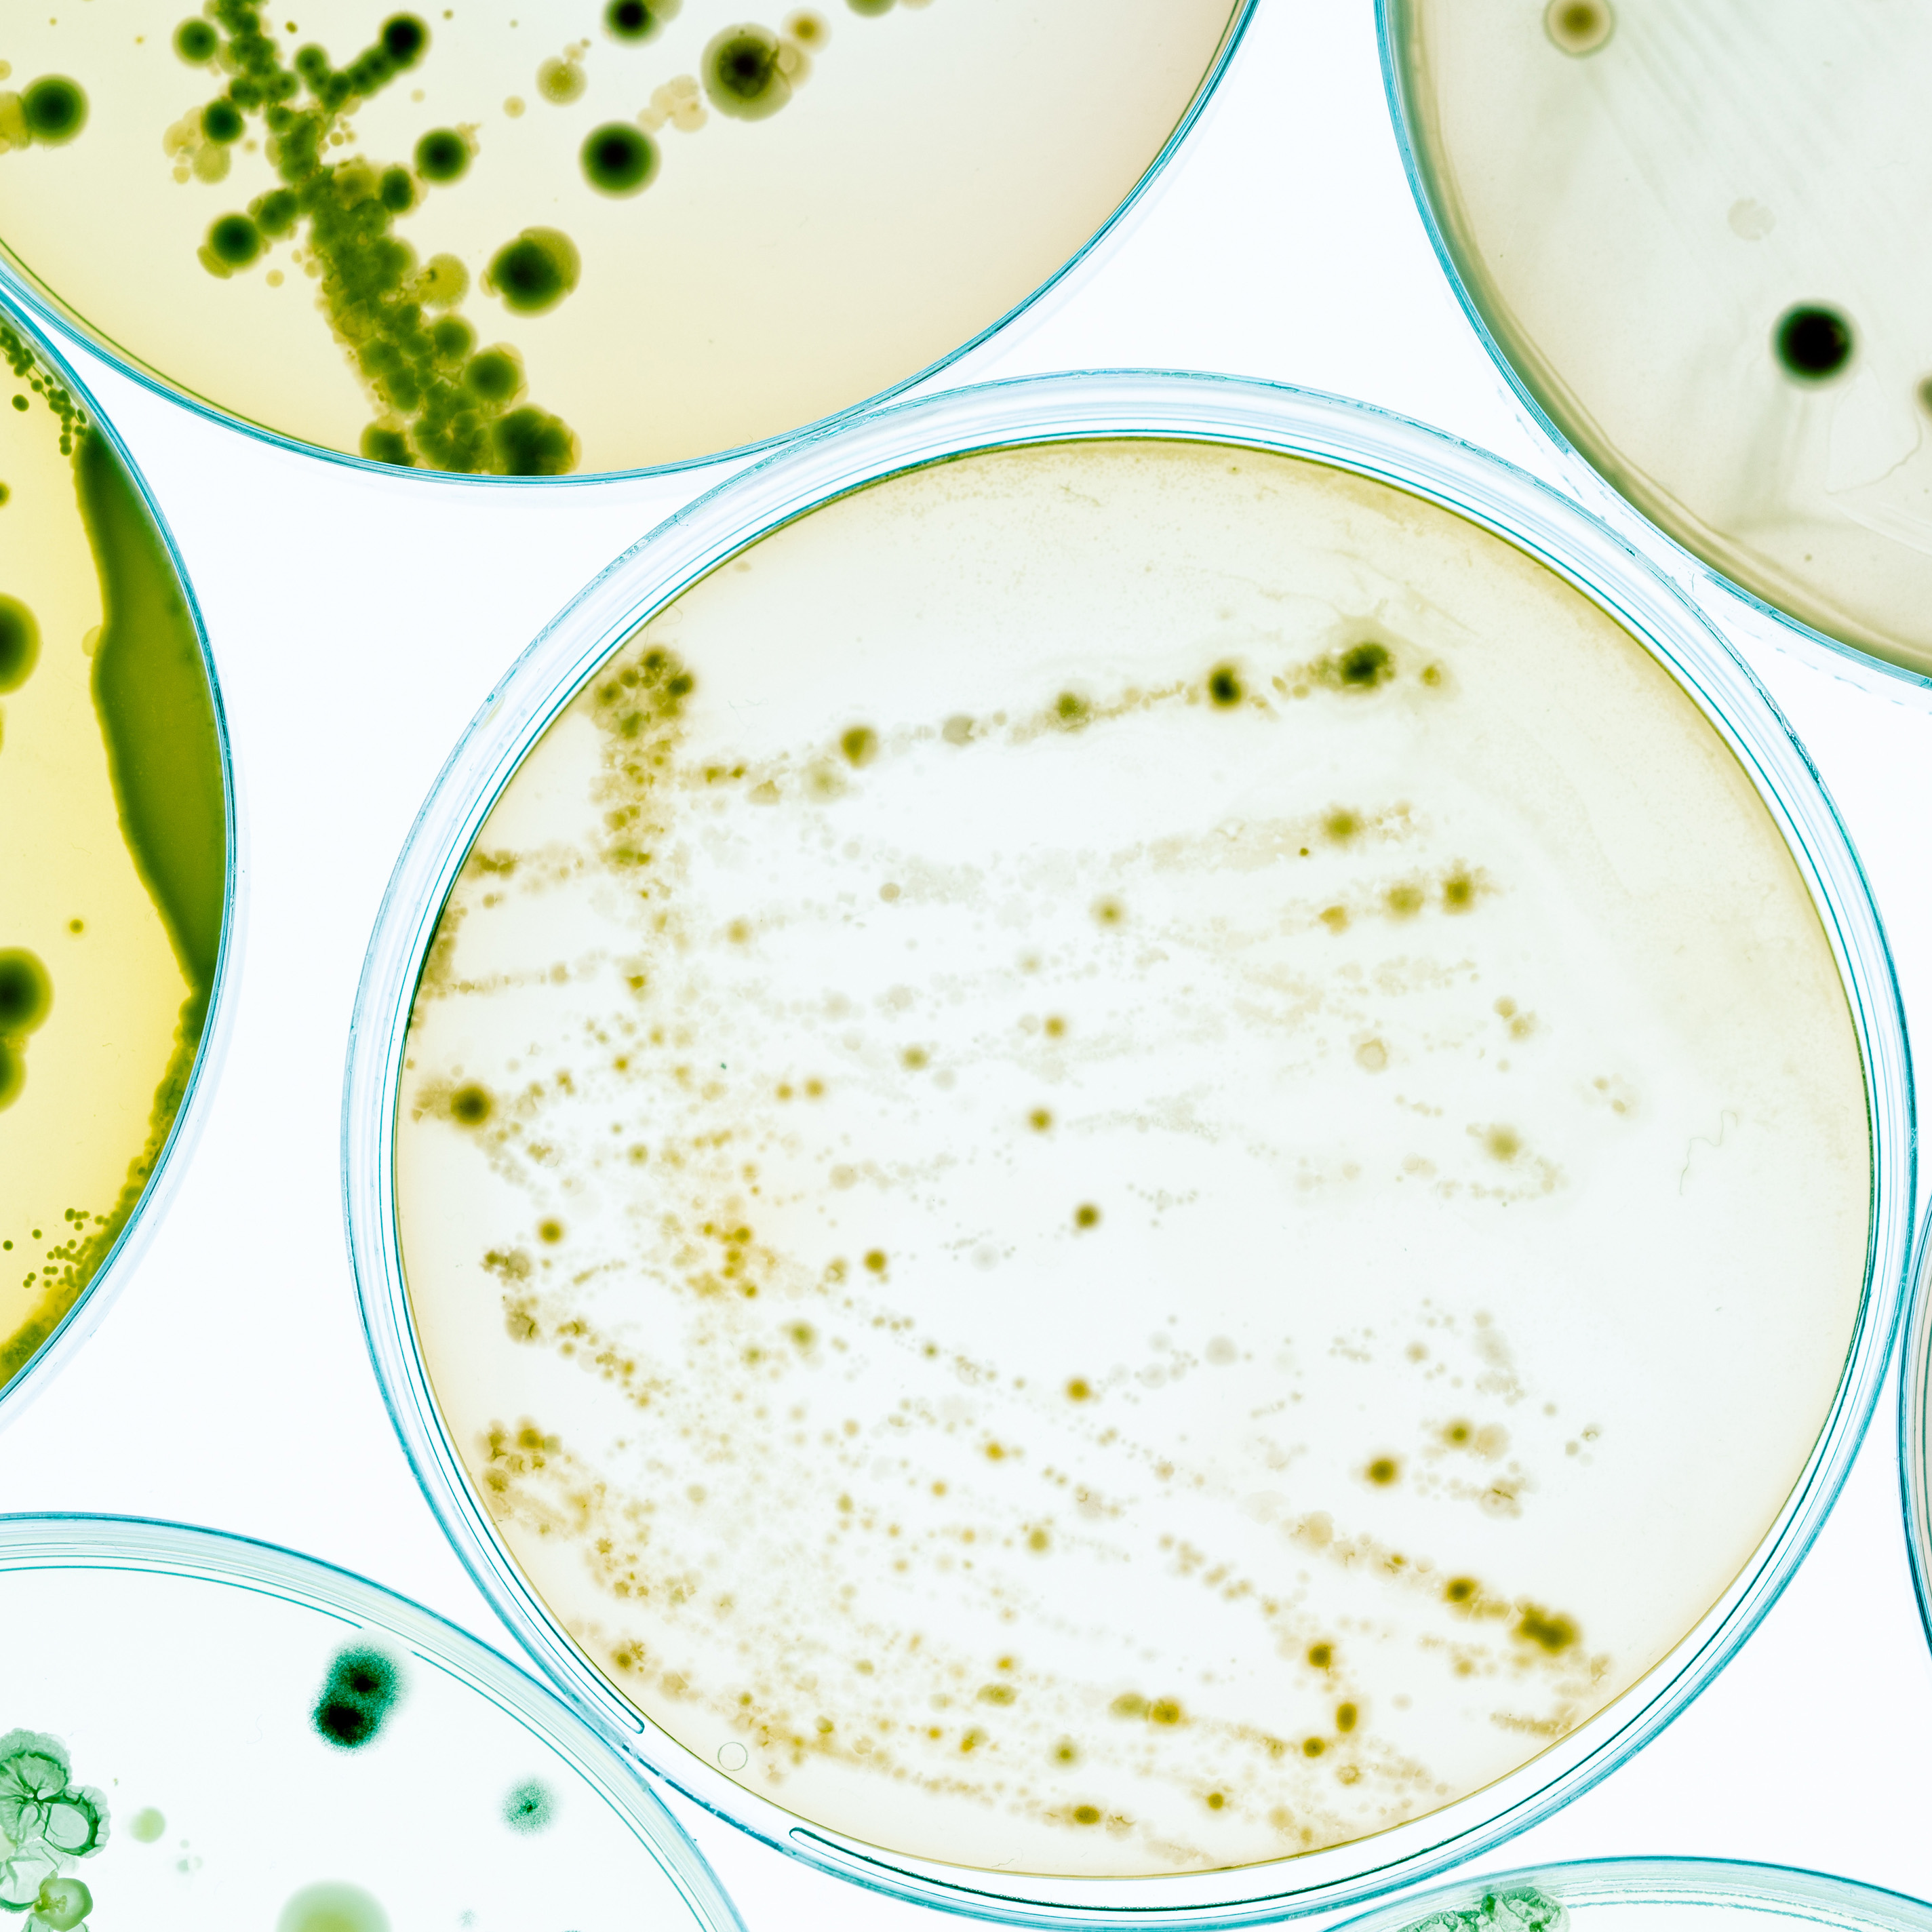

We equip, empower, and inspire clinicians to help patients achieve their best health.
Nothing is more critical to human flourishing than health. And nobody is more on the front lines in this battle than the HCPs serving people in need.
Our job is to help them with Making Health–Human. And that starts with remembering that doctors are people too.

Whether crafting tools from scratch or adapting and localizing pieces from other markets, we are experts at medical storytelling and building the flexible and interactive tools your field team will actually use—and HCPs will notice.
Trust is the foundation of every HCP relationship. And in a world of info overload, it is only getting harder to earn. Our medical team crafts stories that resonate. Unbiased. Evidence-based. Human. We make complex science easy for your HCPs to understand and easy to trust.
While digital teams build out backends that enable greater HCP personalization, many marketers don’t know where to start. We develop the ecosystem strategy and dynamic assets needed to get the most out of your omnichannel approach.
We excel where others struggle—with that rare blend of precision, creativity, and depth of medical expertise required for your communications to be accurate, strategic, engaging, and compliant.
Everything that we do starts with asking WHY. Our strategists dig into your business challenges and medical context to bring their best, tailored advice in a holistic action plan. The right expertise at the right time—to simplify your life, not overcomplicate it.
When we adapt assets from other markets or international teams, we keep it compliant and strategic. It’s not copy and paste—our team ensures that materials resonate with your local needs while adhering to local requirements.

Our team of communication experts are
ready to help you connect with clinicians
and drive real results.
Data stories, creative campaigns, and medical education programs. We know how to reach HCPs.
View Our Full Portfolio
Patients, doctors, or consumers. Regardless of who we’re talking to, one thing remains the same; people are people. And there are two truths about people. One, we all deserve respect, and two, we love stories. Outpost379 dives deep into the emotions and authentic human narratives that matter, ensuring our messaging doesn’t just inform but deeply connects.
We are humbled by the humans we serve—patients, families, and the professionals dedicated to their well-being.
And we strive to always treat medical conditions—as well as humans and the human condition broadly—with respect.
We pride ourselves on being level-headed and pragmatic, to “calm the chaos” both for our clients and our audiences. We simplify the complex of science and healthcare.
And in our day-to-day interactions, we strive to be clear, concise, organized, and solution‑oriented. We keep it real. We help land the plane.
We believe it is possible to do good for our clients and society at the same time. We align our efforts to causes that improve our world, both in the clients we partner with and how we execute the work.

President

VP, Medical & Strategy

Executive Creative Director

VP, Client Services

VP, Consumer & Business Strategy

Vice President




We strive to partner with suppliers who reflect values of representation, fairness, and social responsibility. By actively sourcing from diverse- and women-owned businesses, and setting ethical procurement standards, we amplify underrepresented voices while ensuring environmental integrity at every step of the supply chain. Our holistic approach makes health human not just in our brand, but in the communities and ecosystems we serve.
We respectfully acknowledge that Outpost379 is located on the Treaty 20 Michi Saagiig territory and in the traditional territory of the Michi Saagiig and Chippewa Nations, collectively known as the Williams Treaties First Nations.
We respectfully acknowledge that the Williams Treaties First Nations are the stewards and caretakers of these lands and waters in perpetuity, and that they continue to maintain this responsibility to ensure their health and integrity for generations to come. We are all Treaty people.
As Outpost379, we are committed to fostering respectful relationships and supporting reconciliation efforts that uphold the rights and dignity of Indigenous peoples. We strive to ensure that our initiatives, partnerships, and community spaces reflect inclusivity, celebrate cultural diversity, and contribute to a shared vision of connection and mutual respect.
In the spirit of reconciliation, we pledge to learn, listen, and act in ways that support the aspirations of Indigenous communities while working together to build a vibrant and thriving space for everyone.
Valerie Smith
info@outpost379.com
705.761.0625
